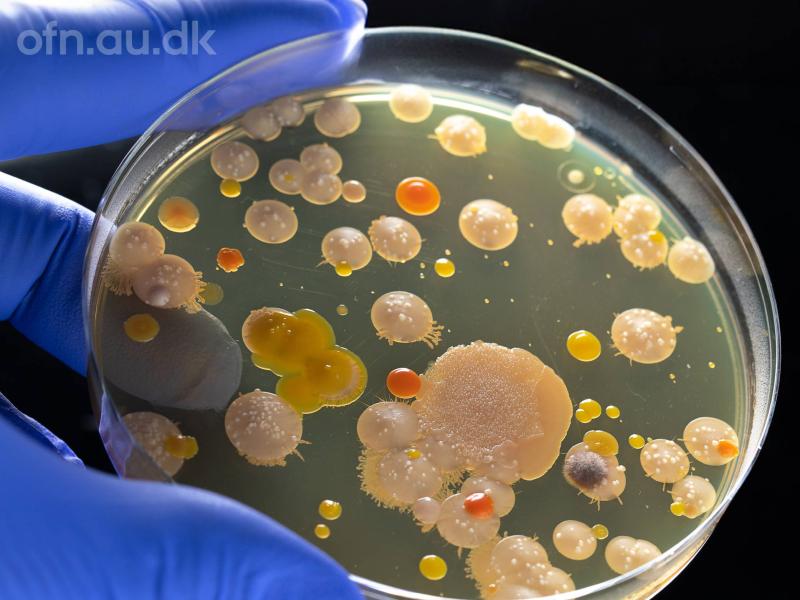

Kom til en aften om anitbiotikaens påvirkning af vores organisme.
- Date
- Tid
- 18:45 - 21:00
- Pris
- Gratis adgangsbillet: Gratis
- Sted
- Vandrehallen
- Bibliotek
- Hillerød Bibliotek
- I samarbejde med
- Aarhus Universitet
- Adresse
-
Christiansgade 1
3400 Hillerød
Danmark
Ditlev Brodersen, professor i molekylærbiologi ved Institut for Molekylærbiologi og Genetik, Aarhus Universitet og Hans Jørn Kolmos, professor i klinisk mikrobiologi ved Klinisk institut, Syddansk Universitet indvier os i en verden af mikroorganismer.
Et af de største fremskridt i lægevidenskaben er opdagelsen af antibiotika, men hvordan virker de egentlig og hvorfor rammer de ikke vores egne celler? Hør om bakterier, antibiotika og om mulige løsninger på de fremvindende resistente bakterier.